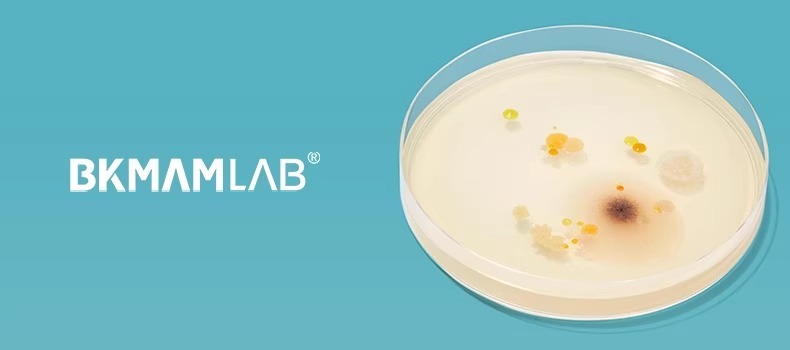

bkmamlab TCBS培養(yǎng)基平板 60mm
當前位置:首頁>
-1.html">A PHP Error was encountered
Severity: Notice
Message: Undefined index: id
Filename: views/product_detail.php
Line Number: 53
A PHP Error was encountered
Severity: Notice
Message: Undefined index: cat_name
Filename: views/product_detail.php
Line Number: 53